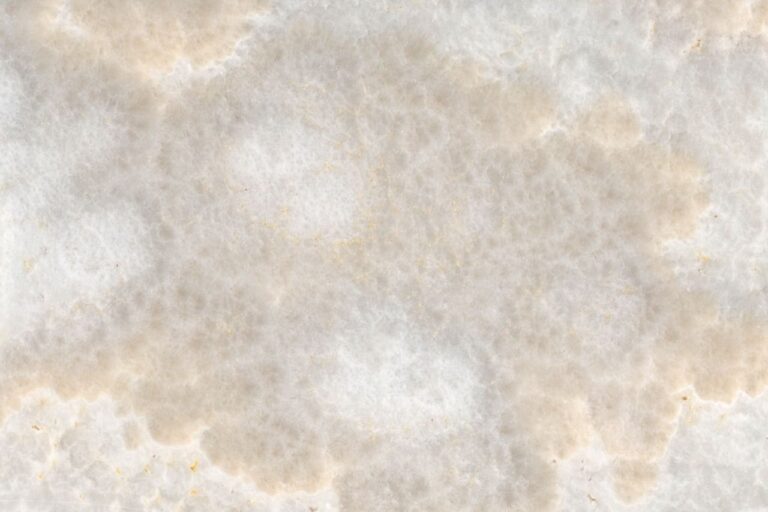

Light, Color, and Character in Onyx Stone
A natural masterpiece that elevates interiors with light, texture, and distinction.

Light Caught in Stone

|
Formed over time from mineral-rich water in quiet limestone caverns, onyx reveals a rare translucence that captures and diffuses light. Gentle bands of color create luminous surfaces that radiate warmth and quiet sophistication, making each piece a natural statement in refined design. |
Onyx Collection
What Set Apart Citatah's Onyx Stone?
Translucent Drama
Light passes through the stone, creating luminous surfaces that cast a gentle glow and transform surrounding spaces.
Flowing Veins
Graceful layers and flowing bands reveal natural rhythm, intricate movement, and visual depth unique to every slab.
Museum-Grade Aesthetics
A heritage material prized for sculptural beauty, luxury, and refined presence across both classic and contemporary settings.
Accent-First Versatility
Ideal for feature walls, counters, and panels, delivering striking focal points that elevate interiors and draw immediate attention.
Curated Color Range
From warm honey through cool jade, a considered palette of tones refined for lasting, sophisticated, and timeless design.
Onyx Stone Applications
Solutions for Every Design Need
Why Choose Citatah for Onyx Stone?
Elevate your projects with Citatah Onyx—expertly sourced, precisely matched, and engineered for luminous, statement-making installations.
Endless Stone Selections, One Trusted Source
Quartzite Stone
The Perfect Blend of Beauty and Durability
Quartzite stone is a naturally occurring metamorphic rock that is highly valued for its strength, durability, and beauty. Formed from sandstone that undergoes high pressure and heat deep within the Earth, quartzite contains high levels of quartz, giving it its unique crystalline structure and making it one of the hardest natural stones available.
Unlike engineered quartz, which is made from powdered rock and resins, quartzite stone is a natural masterpiece, boasting striking colors and patterns that are favored among architects and designers.
Citatah’s Worldwide Collection of quartzite stone offers a wide variety of colors, textures, and finishes, making it a versatile material for a range of architectural and design applications. Whether you need a durable countertop, elegant flooring, or a stunning feature wall, Citatah’s quartzite selection elevates your design with its natural beauty and unmatched resilience.
Citatah supplies premium marble not only throughout Indonesia but also to international markets in the U.S., Middle East, Australia, and Europe. From architectural firms to developers, our clients trust us to deliver stone products with global quality and local character.